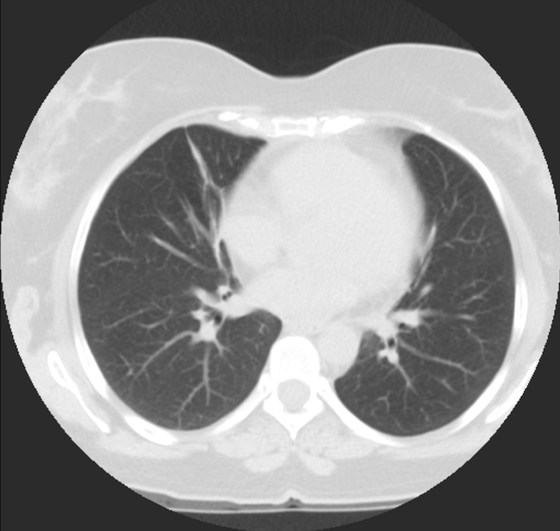
TC

En esta sección nos dedicaremos a la radiografía simple del Tórax. Iremos introduciendo casos de manera periódica con diversa semiología, así el objetivo es día a día quedarnos con un concepto radiológico fundamental, que luego nos sea de ayuda en nuestra práctica clínica rutinaria.
Para empezar:
- Compobar si la radiograf´a es postero-anterior (PA) o antero-posterior (AP).
- La posición estándar es PA, de modo que las estructuras mediastínicas (incluido el corazón) quedan más cerca de la placa radiográfica y están menos magnificados. La AP se suele realizar en los pacientes encamados que no puede moverse, como puede ser en la UCI.

Empecemos, ¿qué ves?


- Comprobar que la placa está bien centrada e inspirada (6 arcos costales anteriores ó 9 posteriores).
- Abdomen y Diafragma
- Partes blandas y estructura ósea.
- Mediastino con silueta cardiaca.
- Parénquimas pulmonares (por separado)
- Comparar un pulmón con otro.
Seguir esta sistemática, dejando el pulmón para el final no nos olvidaremos de lo más importante.
Regla: Acaso Tiene Mucha Patología Pulmonar (Abdomen, Tejidos blandos y hueso, Mediastino, Pulmón por separado, Pulmón bilateral)
Nota: ¡¡¡No olvidar la placa lateral!!! La regla a seguir es la misma. Leer abdomen y diafragma, examinar parte posterior, tejidos blandos y subir por la columna; tráquea y descender por mediastino. Finalmente pulmones.
Solución: Es un estudio Normal. Silueta cardiomediastínica y parénquimas pulmonares sin alteraciones significativas.
CASO: sospecha de neumonía.

Hallazgos:
- En un principio podríamos decir que existe un aumento de densidad retrocardiaco que podría ser compatible con condensación neumónica a dicho nivel, sin embargo estamos ante una placa poco inspirada, lo cual puede llevarnos a cometer errores diagnósticos.
- Se recomendó volver a realizar la radiografía, observar a continuación:

Ya no se observa el aumento de densidad retrocardiaco, la placa es normal.
INSPIRACIÓN: Una placa bien inspirada es aquella en la que se observar 6-7 arcos costales anteriores o 10-11 arcos costales posteriores. Lo contrario puede producir imágenes falsas de condensaciones o de seudocardiomegalia.
CASO: Operada de esofaguectomia y reconstrucción con coloplastia hace 3 meses. Sintomas de neumonía.

Hallazgos:
- De inicio llama la atención una densidad practicamente total del todo el hemitórax izquierdo, lo cual podría hacernos pensar que estamos ante una posible neumonía.
- Sin embargo el tórax está no está bien centrado, observar como la clavícula izquierda se encuentra casi en la mitad del pulmón, por tanto lo que vemos blanco es el mediastino ya que el tórax está rotado.
CENTRAJE:
El correcto centraje se determina comprobando que las extremidades internas de ambas clavículas equidistan de las apófisis espinosas vertebrales.

Mismo paciente, al cual esta vez se le ha tomado una radiografía en PA y en sedestación. Observar como las clavículas están equidistantes a las apófisis espinosas y como ha desaparecido el velamiento del pulmón izquierdo.
Por otra parte, paciente presenta una cardiomegalia y un discreto ensanchamiento del mediastino es probable relación con cambios postquirúrgicos.
CASO: Dolor súbito en paciente asmático.

- Por la clínica presentada, debemos descartar un posible neumotórax. Sin embargo estamos ante una placa radiográfica con mala técnica.
- Se recomendó volver a realizar la radiografía, observar a continuación:

EXPOSICIÓN:
La penetración es la correcta cuando podemos visualizar la vértebras en su totalidad y las costillas a través del corazón.
El contraste es el adecuado si se pueden difrenciar adecuadamente estructuras con diferentes densidades: partes blandas, plumón y esqueleto.
La definición es buena si conseguimos que el paciente esté totlamente quieto durante la realización de la placa.
CASO: Revisión.

Hallazgos:
- Mastectomía derecha.
- Resto del estudio sin hallazgos de significación.
RECUERDA LA SISTEMÁTICA PARA NO OLVIDAR NINGUN HALLAZGO. A esta paciente le han extirpado la mama derecha, motivo por el cual se observa una asimetria entre las densidades de las bases pulmonares.
CASO: Operada de cáncer de mama izquierda en revisión.


Hallazgos:
- Prótesis mamaria izquierda (obsevar el aumento de densidad homogéneo y de bordes bien definidos en la placa PA y lateral)
- Parénquimas pulmonares y silueta cardiomediastínica sin alteraciones significativas.
CASO: Revisión en paciente con tratamiento quimioterápico.

Hallazgos:
- Reservorio subcutáneo en hemitórax izquierdo con bucle del catéter a nivel subclavio. Extermo del catéter en vena cava superior.
CASO: Revisión de cáncer mamario.


Hallazgos:
- Parénquimas pulmonares y silueta cardiomediastínica sin alteraciones.
- Expansor mamario proyectado sobre silueta mamaria izquierda.
Un expansor es una envoltura vacía con una válvula incorporada que se usa tras una mastectomía. Esa envoltura se llena gradualmente a través de la válvula con solución salina con la finalidad de estirar el tejido y formar una cavidad y así proporcionar el espacio óptimo para un implante mamario futuro.
CASO: Pediátrico de más de 2 años tratado por porceso oncológico que ha comenzado con febricula y tos.

Hallazgos:
- Parénquimas pulmonares y silueta cardiomediatínica sin alteraciones significativas. No hay foco neumónico.
- Catéter reservorio subcutáneo con extremo distal en aurícula derecha.
- Resección de la porción anterior de la 6ª costilla. Suponemos que es ahí donde radicaba su proceso de base
CASO: Cazador….


Hallazgos:
- Material de alta densidad proyectadas sobre ambos hemiafragmas, compatibles con perdigones.
- Resto sin hallazgos.
CASO: Preoperatorio.


Hallazgos:
- Fractura en 8º arco costal derecho.
- Aumento de densidad en base izquierda con pérdida de volumen y tracción del hemidiafragma izquierdo en relación con atelectasia.
CASO: Fumador a control.


Hallazgos:
- Paciente con signos de EPOC tipo enfisema y tractos fibrosos: fibroenfisema.
- Cisura de la acigos como variante de la normalidad.
- Adenopatía calcificada en hilio izquierdo.
CISURA DEL LÓBULO DE LA VENA ÁCIGOS:
Indica una variante de la normalidad. El lóbulo de la vena ácigos se crea cuan un vena ácigos desplazada hace un fisura profunda en el pulmón. En la placa simple se ve como una línea fina que cruza el ápex del LSD.


ÁREAS ESCONDIDAS DEL PULMÓN:
Algunas áres del tórax requieren especial atencion, ya que existe patología que puede pasarse por alto:
- Zonas apicales
- Hilios pulmonares
- Zona retrocardiaca.
- Zonas debajo del diafragma.

CASO: Fumador con astenia y fiebre de 38 ºC de 4 días de evolución que no cede con paracetamol.


Hallazgos:
- Hilio derecho convexo e imágenes nodulares en hemitórax derecho que podría corresponder a proceso tumor con adenopatías hiliares. Recomendar TC.
Recordad: el hilio derecho tiene un morfología cóncava o de libro abierto y ésta es más constante que la del hilio izquierdo, el cual posee una morfología más variable.
Observa en la siguiente placa un hilio derecho normal.

CASO: Febrícula y tos de 4 días de evolución.


Hallazgos:
- En la placa PA se observa una asimetría en los hilios pulmonares, el hilio izquierdo tiene una densidad aumentada.
- Tras examinar la placa lateral se observa un aumento de densidad en la columna que puede ser compatible con una condensación, es el signo de la desnificación vertebral.
SIGNO DE LA DENSIFICACIÓN VERTEBRAL: En la radiografía lateral normal, la densidad de la columna torácica tiende a disminuir desde la parte superior hasta el diafragma; la alteración de ese patrón por la presencia de una densidad superpuesta a la columna, indica la existencia de una consolidación pulmonar. Este signo adquiere especial valor cuando en la proyección posteroanterior la consolidación está oculta en el espacio retrocardíaco o en la base pulmonar.
HILIOS PULMONARES. Los hilios normales son:
- Posición normal: el izquierdo es más alto que el derecho.
- Igual densidad.
- El derecho tiene una forma cóncava. El izquierdo es más variable.
- Vasos y ramas normales.
Causas que aumentan el tamaño y desnidad de los hilios:
A- Unilateral: Infección (TB, virus, bacteria), Tumor (carcinoma, linfoma, metastasis), Vascular (aneurisma de la art. pulmonar o estenosis).
B- Bilateral: Sarcoidosis, Silicosis, Infección, Tumor (linfoma, metástasis), Vascular (hipertensión pulmonar, EPOC, enfermedad mitral, shunt…).
CASO: Niño con sensación disnéica que ha ido incrementado en la última semana.


Hallazgos:
- Se observa un ensanchamiento mediastínico a expensas de una masa que desciende el hemidiafragma y borra el borde derecho del corazón.
- En la placa lateral se observa la posición de la masa en posición anterior.
¿ES UNA MASA MEDIASTÍNICA?
Cuando se observa una masa en la placa de tórax, es posible que se localice en el mediastino. Para saber si es una masa mediastínica aquí tenemos unos objetivos a analizar:
- ¿Es una masa mediastínica?
- ¿Es anterior, media o posterior?
- ¿Es posible definir si tiene grasa, aire o líquido?
1)- Las siguientes características indican que la lesion se origina en el mediastino:
- Al contraio que en el pulmón, una masa mediastínica no contiene broncograma aéreo.
- Los márgenes con el pulmón son obtusos.
- Las líneas mediastínicas estarán interrumpidas.
- Pueden estar asociadas anormalidasdes espinales, costales o esternales.

2)- El mediastino puede dividirse en anterior, medio y posterior (la separación es virtual, no hay tejido ni plano que separe estos tres compartimentos). Esta división nos será util a la hora de realizar los diferentes diagnósticos diferenciales.
- En la placa lateral el compartimento anterior y medio se separa dibujando una línea imaginaria anterior a la tráquea y posterior a la vena cava.
- El compartimento medio y posterior se separan dibujando una línea imaginaria que pasa 1cm posterior al borde anterior de los cuerpos vertebrales.

MEDIASTINO ANTERIOR:
Podemos localizar el timo, tiroides, ganglios linfáticos, aorta ascendente, arteria pumonar, nervio frénico. Lo más frecuente es encontar lesiones que afecten al timo o a nódulos linfáticos
Regla de las 4 T’s.
- Timo
- Teratoma
- Tiroide
- Terrible linfoma.
Signos que definen una masa mediatínica Anterior:
- Desplazamiento de las línea mediastínica anterior
- Obliteración del espacio retroesternal.
- Obliteración de los ángulos cardiofrénicos.
- Signo del hilio oculto.
- Borramiento/aumento de densidad de la aorta ascendente.
Nota: En la obliteración del espacio retroesternal se ve un ensanchamiento mediastínico anterior en la proyección PA, mientras que en la lateral se la obliteración/ocupación del espacio retroesternal. Este signo también puede observarse en personas obesas con ocupación de dicho espacio por grasa.

DCHA: Espacio retroesterna normal ocupado por aire.
NOTA: MASAS QUÍSTICAS:
El mediastino anterior es una localización importante para masas quísticas:
- Totalmente quísticas: Quistes tímicos.
- Quíste + Componente sólido: Linfoma o Timoma quístico.
- Quiste con septos (realzados con contraste): Tumor germinal.
CASO: Chico joven con sensación disneica.


Hallazgos:
- Se observa un ensanchamiento mediastínico a expensas de una gran masa que produce una ocupación/obliteración del espacio retroesternal y además se observa el signo del hilio oculto en la PA. Por estos hallazgos se concluye que la masa se encuentra en el mediastino anterior
- Existe ademas engrosmiento/derrame pleural izquierdo.
Nota: El caso se trataba de un linfoma.
SIGNO DEL HILIO OCULTO: es un signo visible en la radiografía posteroanterior de tórax que permite reconocer si una masa es hiliar o mediastínica.
- Cuando la masa es hiliar, está en contacto con la arteria pulmonar y la borra.
- En cambio, cuando podemos seguir viendo los vasos a través de la masa, entonces la lesión no es hiliar, sino que se encuentra anterior (lo + frec) o posterior al hilio.

CASO: Fumador con sindrome constitucional.


Hallazgos:
- En el parénquima pulmonar se observa un masa en LID admás de múltiples nodulos pulmonares dispersos bilaterales en suelta de globos por metástasis.
- Se observa un ensanchamiento mediastínico por una masa (notese el ángulo obtuso que forma con el parénquima pulmonar) y desplaza/borra la línea de la acigos y la paraverebral izquierda. En la lateral se ve como borra la aorta ascendente y ocupa el espacio retroesternal. Podemos decir que se localiza en el mediastino medio y anterior(ver Rx lateral).
MEDIASTINO MEDIO:
Contiene: nódulos linfáticos, tráquea, esófago, vena acigos, vena cava, posterior del corazón y arco aórtico.
La mayoría de masas mediastínicas consisten en quístes de duplicación o adenopatías.
Lesiones con contenido quístico pueden ser quistes de duplicación (esófago o bronquiogénico), adenopatías necrosadas o inclusive colecciones post pancreatitis.
Signos que definen una masa mediatínica Medio:
- Ensanchamiento de las líneas paratraqueales.
- Desplazamiento del la línea acigoesofágica derecha.
- Borramiento de la aorta ascendente.
- Borramiento de la línea paravertebral izquierda.
- Lateral: signo del donut
- Masa posterior a la tráquea.
NOTAS: Lesiones en mediastino medio.
- Sólidas: adenopatías, quistes de duplicación.
- Con grasa: lipoma o pólipo esofágico.
- Fluido: quistes de duplicación, nódulos necróticos, receso epicardico, causas retroperitoneales (pancreatitis por ejm).
CASO: Preoperatorio.


Hallazgos:
- Se observa un casquete y tractos apicales en probable relación con TBC antigua.
- Se ha producido una pérdida de volumen del LSD que ha traccionado el hilio derecho, el cual se encuentra al mismo nivel que el izquierdo.
CASO: Preoperatorio de hernia abdominal.


Hallazgos:
- Lobulación anteromedial hemidiafragma derecho.
- Atelectasia laminar segmento anterior LSD.
- Hemitórax izquierdo sin alteraciones radiológicas significativas.
Algunas causas que elevan el hemidiafragma.
- Atelectasias.
- Eventración/hernia.
- Idiopático, variante de la normalidad (lado derecho más elevado, lobulación del diafragma).
- Enfermedad inflamatoria del abdomen: Absceso subfrénico, perinéfrico, hepático o esplénico; pancreatitis, colecistitis…
- Distensión de estómago.
- Signo de Chilaiditis (interposición del colon entre hígado y diafrágma derecho).
- Parálisis del hemidiafragma: nervio frénico, plexo braquial, médula cervical por proceso patológico, traumatismo, cirugía.
- Enfermedad pleural: pleuritis aguda, empiema, fibrosis, mesotelioma…
- Postoperatrio: lobectomía, neumonectomía, pericardiectomía.
- Hematoma subfrénico (por rotura del hígado o bazo).
- Escoliosis (del lado de la concavidad).
- Masa subfrénica (engrosamiento, quiste, absceso de hígado o bazo, carcinoma de estómago).
CASO: Preoperatorio hernia abdominal (sí, igual que el anterior).


Hallazgos:
- Atelectasia en LID que tracciona el hemidiafragma derecho y produce una pérdida de volumen del hemitórax.
- Es importante hacer el diagnóstico diferencial entre atelectasia y resto de causas que elevan el hemidiafragma.
SIGNOS GENERALES DE ATELECTASIA:
La atelectasia pulmonar es una explansión incompleta de todo o parte de un pulmón. El término colapso es sinónimo y suele utilizars idistintament con el de atlectasia, especialmente cuando es grava o se acompaña de un aumento evient ede la opaciodad del pulmón.
Signos indirectos: Son el cojunto de datos secundarios a la périda de volumen de una parte dle pulmón. Se relacionan con los mecanismo de compensan la reducción de la presión intrapleural.
- Desplazamiento de estructura hacia la atelectasia. En nuestro ejemplo el diafragma se eleva o se desplaza hacia el colapso.
- Hiperinsuflación compensatoria del o los lóbulos adyacente al colapsado, con menor atenuación y menor número de vasos por unidad de volumen. Este singo está presente en colapsos crónicos.
- Incremento local de la densidad pulmonar.
Signos directos:
- Signos bronvasculares. A medida que el pulmón pierde volumen, los vasos y bronquios en el área atelectásica se agrupan. Este es uno de los hallazgos más precoces y sutiles de la atelectasia.
- Desplazamiento de las cisuras interlobulares en dirección al lóbulo afectado, con ciertas particularidades para cada lóbulo. Es uno de los signos más fiables y fácilmente reconocibles de las atelctasias.
CASO: Preoperatorio.

Hallazgos:
- Aumento de densidad trianqular en LSD con pérdida de volumen, tracción de la cisura, el hilio derecho y leve desplazamiento mediastínico homolateral en relación con atelectasia.
CASO: niño de 12 años con fiebre.

Hallazgos:
- Se obsrva un discreto aumento de densidad retrocardiaco que tracciona del hilio izquierdo y lo desciende. Además se observa en la base izquierda un tracción de la pleura pulmonar.
- Hallazgos compatibles con atelectasia.


CASO: cáncer de mama. Control anual.

Hallazgos:
- Se observa un aumento de densidad con agrupación broncovascular que produce un borramiento del borde cardicaco derecho; hallazogos compatibles con atelectasia en el lóbulo medio. Véase el TC a continuación:
CASO: Control preoperatorio.


Hallazgos:
- Aumento de densidad en el vértice del pulmón izquierdo, debido a un casquete apical que produce pérdida de volumen del LSI con elevación del hemidiafragma.
- Catéter reservorio derecho con extremo en vena cava superior.
- Material de cementación en cuerpo vetrebral dorsal.
SIGNO DEL CASQUETE APICAL: Puede ser debido a numerosas causas, sobre todo por lesiones residuales tuberculosas, que suelen acompañarse de otros hallazgos como tractos fibrosos pleuro-parenquimatosos, pérdida de volumen en el lóbulo superior o granulomas.
IMPORTANTE: En caso de se acontecer un signo del casquete apical en el lado izquierdo en un paciente con trauma torácico, hay que descartar la existencia de una rotura aórtica.
CASO: Paciente con disnea.


Hallazgos:
- Se observa una imagen retrocardiaca con un nivel hidroaéreo que desvía la línea paramediastínica. Estos hallazgos son compatibles con Hernia de Hiato.
- El resto del estudio no muestra otros hallazgos de significación.

CASO: Paciente con insuficiencia cardiaca y antecedentes de traumatismo costal derecho.


Hallazgos:
- Fracturas costales hemitórax derecho con formación de callo.
- Cardiomegalia global con líquido en cisura y pequeño derrame pleural izquierdo en probable relación con fracaso cardíaco.
- Osteoporosis columna dorsal con disminución de altura del cuerpo vertebral de probable origen osteoporótico.
- Fractura tercio distal clavicular derecha con acabalgamiento de fragmentos.
Hay que valorar siempre el tamaño cardiaco. La relación cardiotorácica se obtiene realizando la división entra la longitua transverasal del corazón y el diámetro interno torácico mayor. Si es mayor a 0,5 se considera que existe cardiomegalia.


CASO: Postoperotrio de cirugía cardiovascular. Control.


Hallazgos:
- Sutura metálica de esternotomía media.
- Cardiomegalia global con aumento del cono de la pulmonar y prótesis valvular.
- Consolidación con broncograma aéreo en ambos lóbulos inferiores más evidente en el lado derecho donde se acompaña de pérdida volumen y derrame pleural.
La localización de las válvulas cardiacas pueden determinarse mejor en la radiografía lateral. Tras trazar una línea desde el apex cardiaco a la carina, lás válvulas se sitúan:
- Arriba: vávula pulmonar y aórtica.
- Abajo: mitral y tricuspide

CASO: Paciente oncológica con disnea.

Hallazgos:
- Ademas de un catéter reservorio subcutáneo, se observa un derrame pleural izquierdo.
¿Cómo sabemos qué es izquierdo y qué es derecho si solo disponemos de una placa lateral? Pues bien, podemos definir tres signos:
Signo de la costilla grande: recordemos que la placa lateral normalmente se realiza con la parte izquierda del paciente pegada al chasis radiográfico. Por tanto esta parte es más posterior y así se ve más grande en la imagen de placa simple después de incidir el rayo x. Si observamos mejor, vemos como el derrame llega hasta las costillas del lado en el que son más pequeñas, las izquierdas, por tanto es en este lado donde se localiza el derrame.
Signo del desplazamiento vertical: por la misma razón, las costillas derechas se ven más separadas entre sí que las izquierdas, que están menos magnificadas.
Burbuja de la cámara gástrica: se posiciona bajo el hemidiafragma izquierdo.
Comprobemos con la placa PA:

CASO: Disnea.


Hallazgos:
- Perdida de volumen derecho
- Paquipleuritis calcificada izquierda.
- Pinzamiento de ambos senos de predominio derecho.
PAQUIPLEURITIS:
Engrosamiento de la pleura de carácter difuso o circunscrito. Se observa frecuentemente en las pleuresías crónicas y tras pleuresías purulentas tuberculosas en las que el exudado inflamatorio no se ha reabsorbido sino que ha sido sustituido por tejido conectivo. Generalmente es adhesiva y cursa con depósito de cal y osificación. Cuando la paquipleuritis es extensa dificulta la expansión pulmonar durante la respiración.
CASO: Disnea. Paciente con insuficiencia cardiaca.


Hallazgos:
- Cardiomegalia.
- Signo del 3º mogul y doble contorno por crecimiento de la aurícula izquierda.
- Bronquio izquierdo rectificado por crecimiento de la aurícula izquierda (signo de la bailarina).
- En la placa lateral, además se observa elongación aórtica.
- Parénquimas pulmonares sin hallazgos.

Signo del doble contorno: La AI aumentada de tamaño produce un segundo contorno que normalmente no debería figurar (flecha naranja contínua).
Flecha amarilla: cayado aórtico.
Flecha verde: arteria pulmonar.
Flecha azul: ventrículo izquierdo.
Signo del tercer mogul: se refiere a la lobulación anormal del contorno mediastínico izquierdo entre la arteria pulmonar y el ventrículo izquierdo. Pueden producir esta lobulación lesiones cardíacas y pericárdicas (orejuela izquierda aumentada, aneurisma ventricular o de la arteria coronaria, quiste o masa pericárdicos, etc) y también algunos tumores mediastínicos, como timomas. En la imagen, el signo corresponde al crecimiento de la orejuela izquierda (flecha roja). La palabra “mogul” es un término utilizado por los esquiadores para describir un acúmulo mamilar de nieve compacta en una ladera montañosa. El primer mogul corresponde al cayado aórtico (flecha amarilla); el segundo, a la prominencia de la arteria pulmonar (flecha verde); y el cuarto, al contorno del ventrículo izquierdo (flecha azul).
Signo del doble contorno: indicativo de crecimiento de la aurícula izquierda en la radiografía posteroanterior de tórax. La aurícula izquierda no forma parte normalmente del contorno cardiaco derecho en esta proyección; sin embargo, cuando aumenta de tamaño, produce un segundo contorno (flecha narana contínua), además del de la aurícula derecha (flecha naranja discontinua).
Signo de la bailarina: es un signo de crecimiento de la aurícula izquierda visible en la radiografía posteroanterior o anteroposterior de tórax, y consiste en el aumento del ángulo traqueal por levantamiento del bronquio principal izquierdo (flecha rosa). El nombre del signo se debe al parecido de la imagen con la apertura de piernas (spagat) de una bailarina.

CASO: Postoperado de cirguía cardiovascular.


Hallazgos:
- Cardiomegalia.
- En la placa lateral se observa como el VD sobrepasa la entrada de la vena cava inferior.
- Existe redistribución perihiliar, singos de congestión vascualr por fallo cardiaco.
- Suturas de esternotomía media.


Ratio Arteria / Bronquio:
Normalmente, lo vaos en los lóbulos superior son más pequeños que el bronquio que los acompaña con un ratio de 0.85. A nivel de los hilios, son iguales y en los lóbulos superiores son más grandes con un ratio de 1.35.
Cuando hay redistribución de la sangre pulmonar, habrá un ratio aumentado entre la arteria y el bronquio en los lóbulos superiores y medios. Esto se ve mejor en la región perihiliar.
Redistribución:
En una placa normal, con el paciente en posición erecta, los vasos pulmonares que irrigan los lóbulos superiores son más pequeños y escasos que los de los lobulos inferiores.
La vasculatura pulmonar tiene una gran reserva funcional y, en caso de necesidad, puede recrutar vasos que antes esteban «cerrados» o no perfundidos y también puede aumentar el calibre de aquellos que ya estaban «abiertos» o perfundidos. Esto es lo conocemos como redistribucion pulmonar, aumento del calibre y número de vasos, se produce una ecualización de vasos desde las bases hasta los lóbulos superiores.
El término redistribución se usa para placas tomadas con inspiración máxima y posición erecta. En la práctica clínica diaria, a veces esto no es posible y la difencia entre los lóbulos superiores e inferioes es menos evidente. En los pacientes en posición supina, hay una ecualisación o igualidad del flujo sanguíneo entre los lóbulos superiores e inferiore que pueden dar la falsa impresión de redistribuición, En estos casos, lo mejor es compara con placas antiguas.
La redistribución constituye en estadio I del fallo cardiaco congestivo:
- Redistribución. (Estadio I).
- Edema intersticial (Estadio II).
- Edema alveolar (Estadio III).
CASO: Lactante con disnea.

Hallazgos:
- Aumento de densidad perihiliar, bilateral y simétrico compatibles con edema cardiogénico. Estamos ante un edema agudo de pulmón con el singo en Alas de Mariposa.
- Tubo endotraqueal con extremo proyectado sobre cuerpo vetebral de T2.
ALAS DE MARIPOSA: es un signo que inidca fallo cardiaco congestivo, aunque también se puede ver en otras entidadas como las nuemonías por gérmenes no habituales o la hemorragia pulmonar. Está caracterizado por la presentcia de infiltrados perihiliares, bilaterales y simétrico que respetan la perfiferia del pulmón.
Veamos otro ejemplo:


CASO : Paciente con disnea.


Hallazgos:
- Se observan unos parénquimas pulmonares con discreta redistribución perihiliar.
- Pinzamiento del seno costofrénico derecho con signos de edema intersticial, Líneas B de Kerley.
- El edema interticial constitye el Estadio II del fallo cardiaco congestivo.

Las líneas de Kerley son signos visibles en radiografías simples de pacientes con edema intersticial pulmonar. Son líneas finas causadas por líquido o infiltración celular en el intersticio del pulmón. Pueden ser:
- Líneas B de Kerley son de menos de 2cm de longitud localizadas en la cercanía de los senos costofrénicos o en el espacio retroesternal, paralelas entre sí y perpendiculares a la superficie pleural.
- Líneas A son más largas, cruzando las sombras vasculares. Oblicuas en el hilio.
Lás líneas de Kerley están dentro del Patrón Intersticial de afectación pulmonar, son de subtipo Lineal.
Causas de patron intersticial subtipo lineal:
- Edema por presión venosa
- Edema linfático
- Infección con inflamación
- Linfangitis tumoral (linfoma o metastasis)
- Enf. Granulomatosas y colagenosis
- Enf. Por inhalación
VEAMOS A CONTINUACIÓN OTROS PATRONES O SUBTIPOS DE AFECTACIÓN INTESTICIAL.
¿ Qué es el intersticio? El intersticio pulmonar está conformado por una trama de tejido conectivo que le proporciona un adecuado soporte al resto de las estructuras pulmonares. Está dividido en tres compartimentos conectados entre sí:
- Intersticio subpleural: ubicado por debajo de la pleura visceral y que penetra en el pulmón a través de los septos interlobulillares.
- Intersticio peribroncovascular: alrededor de los bronquios y arterias.
- Intersticio parenquimatoso: localizado entre las membranas basales del epitelio alveolar y el endotelio capilar.


En condiciones normales el intersticio no es visible. Se produce por el aumento patológico de uno o todos sus componentes. Podemos definir una serie de patrones o subtipos de afectación intersticial:
- Patrón lineal (visto en el caso anterior).
- Patrón reticular
- Patrón reticulonodular
- Patrón nodular
- Patrón en panal
- Patrón en vidrio deslustrado
– Caso. Patrón reticular: aumento de densidad en forma de malla o retícula.

Causas:
- Cualquiera causa de lineal
- Fibrosis pulmonar
- Enfisema bulloso
- Histiocitosis X
- Neumoconiosis
– Caso. Patrón nodular: opacidades redondeadas de muy pequeño tamaño normalmente difusas, con bordes netos, en número variable.

Causas:
- Granulomatosas: Tuberculosis miliar, Artritis reumatoide, Silicosis, Neumoconiosis, Sarcoidosis.
- Neoplasias: Metástasis (tiroides, riñón y melanoma).
- Otras: Proteinosis alveolar, Amiloidosis, Hemosiderosis, Microlitiasis alveolar.
– Caso. Patrón reticulonodular: las líneas suelen partir de los nódulos.

Causas:
- Neumoconiosis
- Drogas
- Granuloma Eosinófilo
- Sarcoidosis
- Tuberculosis
- Enfermedades Fúngicas
- Esquistosomiasis
- Metástasis (tiroides)
- Linfoma
– Caso. Patrón en panal: Opacidades pulmonares subpleurales con imágenes aéreas quísticas menores de 1cm en su interior con un aspecto reticular. Suele acompañarse de pérdida de volumen por patología restictiva. La presencia de panalización puede significar lesión destructiva final con fibrosis y distorsión de la arquitectura pulmonar de grado severo.


Causas:
- Enfermedades del Tejido conectivo (esclerodermia, artritis reumatoide, dematopolimiositis, polimiositis).
- Fibrosis pulomnar idiopática, Neumonía intersticial usual.
- Histiocitosis X.
- Neumoconiosis.
- Sarcoidosis.
CASO: Paciente inmunodeprimido con Disnea.


Hallazgos:
- En la placa PA hay opacidad difusa bilateral de ambos hemitorax en vidrio deslustrado. En bases pueden intuirse opacidades mutifocales. La placa lateral también muestra la opacidad total del parénquima.
IMPORTANTE: Estos hallazgos son inespecíficos, pero ante un paciente inmunodeprimido, la evidencia de opacidad en forma de vidrio deslustrado, más aun si es de predominio perihiliar y en lóbulos superiores, hay que descartar en primer lugar una neumonía por Neumocistis, que en nuestro medio suele vincularse a pacientes VIH positivos.
VIDRIO DESLUSTRADO: Aumento de densidad difusa que no impiden la visualización de los vasos pulmonares que contienen. Se puede ver en afectación del espacio aéreo y/o del intersticio.
Causas:
- Infecciosas (P.Jiroveci y CMV)
- Neumonía intersticial descamativa.
- Alveolitis alérgica extrínseca.
- Sarcoidosis.
- Neumonía intersticial habitual.
- Proteinosis alveolar.
- Neumonía organizada criptogénica
CASO: Niño de 3 años con tos y fiebre de 38.5ºC que no cede con paracetamol.

Hallazgos:
- Infiltrados perihliares y gran condensación retrocardiaca y en base izquierda con broncograma aéreo compatible con foco neumónico.
- Engrosamiento marcado del intersticio peribroncovascular perihiliar bilateral.
- No hay derrame pleural.
PATRÓN ALVEOLAR:
- Nódulos grandes de más de 0,5 cm de diámetro.
- Mal delimitados, con límites difusos.
- Coalescencia precoz, formando imágenes de condensación.
- Presencia de broncograma y alveolograma aéreo
- Pueden ser localizado afectando solo a una porción o difusos, en donde se afectan la totalidad de los campos pulmonares.
BRONCOGRAMA AÉREO: En una radiografía de tórax normal solo se ve aire en la tráquea y en los bronquios proximales al estar rodeados por tejidos blandos del mediastino. Los bronquios no son visibles. Las únicas estructuras ramificadas visibles en los pulmones son los vasos. El broncograma aéreo consiste en la presencia de los bronquios llenos de aire (visibles como líneas radiolúcidas) rodeados de condensación alveolar. Los broncogramas aéreos agrupados sugieren atelectasia no obstructiva
CASO: Paciente con sospecha de neumonía.

Hallazgos:
- Se observa un aumento de densidad localizado en LSD, que delimita la cisura, compatible con proceso neumónico.
- En el seno del la condensación existen pequeñas imágnes milimétricas radiolúcidas que conforman el signo del alveolograma aéreo.
- No hay derrame pleural.
ALVEOLOGRAMA AÉRERO: son pequeñas zonas de densidad aire en el interior de una condensación neumónica, las cuales corresponden a alveolos libres de condensación. El alveolograma aéreo es, por tanto, signo de condensación alveolar y se ve más fácilmente en la periferia la radiografía o la TC.

CASO: Paciente con fiebre y tos.

Hallazgos:
- Se observa un aumento de densidad que borra el borde cardiaco derecho, produciendo el signo de la silueta. Ante este hallazgo, localizamos la condensación en el Lóbulo Medio.
- Sin otros hallazgos.
SIGNO DE LA SILUETA: Es el más conocido y clásico de los signos radiológicos, y permite reconocer la localización de lesiones pulmonares. No es un signo específico de lesión alveolar, ya que puede verse en tumores, abscesos y otras lesiones. Más que un signo indicador de patología es un signo localizador. El signo de la silueta se refiere a que cualquier opacidad pulmonar que esté en contacto con el borde cardíaco, la aorta o el diafragma, borrará su contorno; por el contrario, una lesión que no esté en contigüidad con estas estructuras, no borrará su contorno (para ver más: http://album-de-signos-radiologicos.com/category/lesion-alveolar/).
CASO: paciente pediátrico de 4 años con fiebre de 38ºC, tos y esputos abundantes de varios días de evolución.

Hallazgos:
- Aumento de densidad que borra el LM, compatible con condensación neumónica a dicho nivel.
- Se obsrva un borramiento del seno costrofrénico derecho compatible con derrame pleural (comparar con el contralateral).
CASO: Dolor abdominal.


Hallazgos:
- Tórax discretamente rotado.
- Se observa una condensación retrodiafragmatica derecha que en la placa lateral se confirma en la parte posterior del LID.
- Existe además un componente de atelectasia con pérdida de volumen de dicho lóbulo,.
- NOTA: Una neumonía puede ocasionar dolor abdominal.
CASO: Paciente ingresado en UCI con signos de insuficiencia respiratoria.

Hallazgos:
- Se observa un aumento de densidad difuso bilateral conformado por múltoples opacidades nodulares mal definidas y coalescentes, de preodominio el en el pulmón derecho.
- Estamos ante una lesión alveolar en el contexto de un SDRA.
PATRON ALVEOLAR DIFUSO: puede verse en Edema agudo de pulmón, SDRA, Edema pulmonar lesional, Neumonía bilateral , Neumonitis física/química, Contusión pulmonar, etc.
CASO: Fumador de 3 paquetes al día con disnea y fiebre.


Hallazgos:
- Llama la atención la hiperclaridad difusa bilateral en ambos pulomones que correponde con un patrón pulmonar destrucitvo por EPOC tipo enfisema.
- Sin otros hallagos.
HIPERCLARIDAD PULMONAR. Lo más frecuente es que pueda ser por:
1)-PATRON DESTRUCTIVO EPOC:
- Diafragmas aplanados y descendidos
- Aumento del espacio aéreo retroesternal
- El diámetro Antero-posterior está aumentado
2)-TEP
- Hiperclaridad pulmonar localizada o difusa por disminución de la vascularización pulmonar en casos de TEP masivos
CASO: Paciente que tras esfuerzos de mucha intensidad siente palpitaciones.

Hallazgos:
- Borramiento de borde cardiaco derecho por Pectus Excavatum.
- Parénquimas pulmonares sin alteraciones radiológicas significativas.
PECTUS EXCAVATUM.


Con una frecuencia de 8 por 1.000 recién nacidos vivos, constituye la más común de las deformidades congénitas de la pared anterior del tórax. Suele estar presente al nacer o comienza a evidenciarse durante el primer año de vida, acentuándose en la adolescencia. Predomina en varones 3:1 y pueden existir antecedentes familiares.
Es una depresión esternal interna, formando una concavidad, consecuencia de una anormalidad en el crecimiento del esternón y de los cartílagos costales. Suele ser asimétrica, de predominio derecho. Su etiología es desconocida aunque puede influir la tracción del diafragma.
Puede estar asociado escoliosis, Marfan, cardiopatía congénita, displasia broncopulmonar, enfermedades metabólicas o del tejido conectivo.
Suele ser asintomáticos. En casos de deformidades acentuadas, pueden causar dificultad respiratoria. La presencia de sintomatología debería hacer plantear un protocolo de estudio rápido.
El diagnóstico es clínico. Con la imagen evaluamos mejor la deformidad, útil en caso de ser necesaria la cirugía.
En la Rx de tórax se observa el borramiento del borde cardiaco derecho y en la placa lateral, la depresión interna del esternón, característicamente del cuerpo esternal y de la apófisis xifoides. En casos más acentuados, el corazón, los pulmones, el esófago y el diafragma pueden estar comprimidos, con desplazamiento del corazón hacia la izquierda y prominencia del tronco de la arteria pulmonar en la proyección PA; hallazgos mas evidentes gracias al TC y las reconstrucciones.
El tratamiento puede ser conservador o eventualmente quirúrgico.


Índice de Haller:
- Medio: 3,2
- Moderado: 3,2-3,5
- Severo: > 3,5 (cirugía).

CASO: Chico jóven que presenta una deformidad en la caja torácia


Hallazgos:
- Deformaidad esternal con desplazamiento anterior compatible con pectus carinatum.
- Sin otros hallazgos a destacar.
PECTUS CARINATUM:
Menos frecuente que el pectus excavatum.
Existe un desplazamiento anterior del esternón.
Puede asociarse a cardiopatías.
Clínica: Dificultad respiratoria e intolerancia al ejercicio.
Variantes:
PECTUS CARINATUM INFERIOR : pecho de paloma
PECTUS CARINATUM SUPERIOR: Sd de Currarino Silverman

CASO: Accidente de tráfico. Golpe centrotorácico.

Hallazgos:
- Se observa una disrupción cortical en el cuerpo del esternón compatible con fractura.

CASO: Sospecha de neumonía.


Hallazgos:
- Pinzameinto del seno costrofrénico izquierdo en relación con derrame pleural.
- Se observa un aumento de densidad en el LSI podría corresponder con una atelectasia. A diho nivel, exista además una banda radiolúcida paratraqueal izquierda, entre la porción superior el cayado aórtico y el parénquima pulmonar, que corresponde al Signo de Luftsichel, hallazgo que refuerza el diagnóstico de atelectasia.

Luftsichel es una palabra derivada del alemán, compuesta por luft(aire) y sichel(hoz). Este signo ha sido descrito en atelectasia de lóbulos superiores, particularmente en atelectasia del lóbulo superior izquierdo. Corresponde al segmento apical del lóbulo inferior izquierdo sobreinsuflado e interpuesto entre el mediastino (cayado aórtico) y el lóbulo colapsado.
http://www.scielo.org.co/pdf/amc/v38n1/v38n1a12.pdf
CASO: Paciento con dolor abdominal difuso y disnea. Se realizó una colonoscopia hace 3 días.


Hallazgos: Observamos un signo indicativo de neumoperitoneo. En este caso, existe presencia de gas por debajo de ambos diafragmas.
NEUMOPERITONEO:
Se definie como la presencia de gas en la cavidad peritoneal, el cual no debería existir en condiciones normales. En la placa de tórax y abdomen podemos ver los siguientes signos más comunes:
- Gas subdiafragmático.
- Signo de Rigler o Doble pared.
- Aire en la placa simple lateral de abdomen.
- Signo de uraco.
- Distensión de asas.
- Otros: signo del balón de fútbol, hígado lucente, signo del ligamento falciforme, V invertida… Etiologias del neumoperitoneo:
A- NEUMOPERITONEO ESPÓNTÁNEO SIN PERITONITIS:
- Iatrogénico (Cirugía, del tracto GI, Antestesis, Terapia respiratoria, Diálisis pertitoneal, Endoscopia, Broncoscpia, Test de Rubien – trompas de falopio).
- Idiopático.
- Perforación del tracto gastrointestinal (úlcera péptica duodenal, neoplasia, E. de Chron, diverticulitis, colitis isquémica u obstrución intestinal, traumatismo, cuerpos extraños)
- Menos frecuente: SDRA, distensión de estómago (aerofagia, gastroscopia…), pseudoobstrucción del colon, diverticulosis, terpia esclerosante de varices…
B- NEUMOPERITONEO CON PERITONITIS:
- Perforación de víscera huecas: úlcera péptica, obstrucción intestinal, diverticulitis, apendicitis, tumor, trauma abdominal, colecistitis enfisematosa, megacolon perforado (Chagas, Hirschsprung).
- Perforación del colon.
- Peritonitis sépticas.
- Enfermedad ulcerosa intestinal.
CASO: Paciente oncológico sometido a gastrostomía. Dolor continuo que no mejora con analgesia.


Hallazgos:
- Aire subdiafragmático derecho compatible con neumoperitoneo.
- En la placa lateral se obserba aire bajo un diafragma que tiene su contorno continuo, corazón no le hace signo de la silueta. Así, podemos identificarlo como el hemidiafragma derecho también en esta proyección.
- Canula de traqueostomía.
- Sin otros hallazgos a destacar.

CASO: Preoperatorio.


Hallazgos:
- Asas de colon bajo el hemidiaframa derecho. Se conoce como signo de chilaiditis.
- El estudio es normal.
CHILAIDITIS:
Se denomina Chilaiditis en honor a Demetrius Chilaiditi, radiólogo griego que definió el signo en 1910.
Se define como la interposición hepatodiafragmática del colon, que suele ser un descubrimiento casual durante el estudio radiológico por otra causa. Suele ser asintomática y cuando el hallazgo cursa con síntomas como dolor abdominal, náuseas, vómitos o estreñimiento, se conoce como síndrome de Chilaiditis.
La chilaiditis constituye una causa de pseudoneumoperitoneo, la cual hay que identificar para evitar más pruebas diagnósticas y tratamientos no necesarios. Otra causa de pseudoneumoperitoneo es la grasa de la cavidad abdominal.

CASO: Paciente jóven asmático con gran disnea súbita (se muestra la evolución radiológica).
Hallazgos:
- Placa: Neumotórax derecho a tensión. Hemitórax derecho más radiolúcido y con colapso del pulmón derecho + desplazamiento del mediastino hacia la izquierda.
- Placa: Persistencia del neumotórax. Periferia radiolúcida seperada del pulmón adyacente más denso por una línea o borde pulmonar evidente. Mediastino normoposicionado.
- Placa: Reexpansión completa del pulmón derecho sin signos de neumotórax. Pequeño enfisema subcutáneo.
NEUMOTÓRAX: Los paciente suelen presentar dolor torácico pleurítico y disnea. El dolor predomina en pacientes sin enfermedad de base; en pacientes con patología pulmonar previa, predomina la disnea. Pueden ser espontáneos o tras traumatismo. Los espontáneos suelen ser secundarios a patología pulmonar (asma, EPOC, bullas, lesiones intersticiales…), aunque también pueden darse en pulmones sanos (primario espontáneo, adolescentes).
Pueden ser:
– ESPONTÁNEOS: Pulmones sanos, Blebs/bullas subpleurales.
– ENFERMEDAD PULMONAR: EPOC, Asma, Enfermedad quística (ej: Lingioleiomiomatosis).
– TRAUMA: Accidente/contusión, Biopsia pumonar, Ventilación mecánica, Cocaína.
Los hallazgos suelen ser:
- Región periférica radiolucente en comparación con el pulmón adyacente
- Línea blanca pulmonar.
- Ausencia de trama o marcas pulmonares en la periferia.
- Signo del seno costofrénico profundo.
- Neumomedistino (Signo de la V de Naclerio) o enfisema subcutáneo.
- Desplazamiento del mediastino: Neumotórax a tensión = ES UNA URGENCIA.
- Si el neumotórax no es claro: hacer la radiografía en espiración, el numotórax es más evidente y el pulmón colapsado más denso.
- Otros: Singo del seno costofrénico profundo.
CASO: Paciente joven con hábito marfanoide. Dolor súbito que aumenta con la inspiración.


Hallazgos:
- Neumotórax derecho.
- Escoliosis en la transición dorsolumbar.
- Resto sin hallazgos a destacar.

RECUERDA: Si el neumotórax no es evidente, hay que realizar una radiografía en ESPIRACIÓN: El neumotorax se ve más radiolúcido y el parénquima colapsado es más denso.
CASO: Dificultad respiratoria tras contusión costal.


Hallazgos:
- Signos radiológicos de enfisema.
- Neumotórax apical derecho, ausencia de vasos en LSD y signos del seno costofrénico derecho profundo.

CASO: Niña con dolor torácico a la inspiración profunda.

Hallazgos:
- Se observa una linea radiolúcemte en el borde cardiaco izquierdo que se extiende bordeando la silueta mediastínica izquierda, el timo y el botón aórtico.
- En el apex, a nivel paratraqueal parece existir también zonas radiolúcidas compatibles también con aire en mediastino.
NEUMOMEDIASTINO:
En la radiografía veremos una radiolucencia delimitando el mediastino, incluyendo grandes vasos, timos, traquea y pared bronquial. Regiones de emfisema subcutáneao pueden ser también reconocidas.
Pequeñas cantidades de aire representadas por radiolucencias lineales o curvilíneas delimitando el contorno mediastínico como:
- Enfisema subcutáneo.
- Aire anterior al pericardio: neumopericardio.
- Aire alrededor de la arteria pulmonar y ramas principales: singo de anillo
- Aire alrededro de la aorta y ramas principales.
- Aire delimitando la pared bronquial: signo de doble pared.
- Diafragma continuo.
- Aire entre la pleura parietal y el diafragma: signo extrapleural.
- Aire en el ligamento pulmonar
- Signo de la V de naclerio.
- Timo elevado (pediatría).
- Haystack sign: aire arriba y debajo del corazon (pediatría).
Causas de neumomediastino:
- Ruptura alveolar: frecuente en personas con asma.
- Perforación esofágica: como las del sindrome de Boerhaave.
- Ruptura de intestino delgado: con disección del aire desde el abdomen hacia el mediastino.
- Otras: barotrauma, trauma cerrado o penetrante, infección.
Tratamiento y pronóstico:
La mayoría de las veces es conservador. Si existe neumomediastino a tensión puede requerir aspiración con aguja.
CASO: Paciente con disnea y fiebre.


Hallazgos:
- Se observan dos colecciones en hemitorax derecho. Una parenquimatosa y otra pleural, la cual se identifica por el cambio de su diámetro máximo en la proyección lateral, mientras que la intraparenquimatosa (rojo) mantiene sus dimensiones.
- Pinzamiento del seno costofrénico derecho.
- Resto del estudio sin hallazgos.



CASO: Preoperatorio.


Hallazgos:
- Crecimiento ventricular izquierdo con elongación aórtica.
- Engrosamiento con pinzamiento pleural postero basal izquierdo con imagen nodular de base pleural.
- Borramiento del borde cardiaco derecho por pectus excavatum. En la placa lateral se observa la depresión interna del esternón y el apéndice xifoides.
La imágen nodular, mejor visualizada en la placa lateral, ¿podría ser un proceso neoformativo? Pues podría, pero no lo es, estamos ante un caso de Atelectasia Redonda, se define así:
A- Engrosamiento pleural.
B- Masa triangular, redonda u ovalada bien definida adyacente a pleura.
C- Signo de la cola de cometa: vasos convergiendo hacia la masa en modo curvilíneo, observar en placa y TC.
D- Otra característca es que la atelectasia redonda se suele observar bien en una sola proyección, a diferencia de la mayoría de nódulos (en nuestro caso, en AP no se obseva bien).

CASO: Preoperatorio.

Hallazgos:
- La radiografía de tórax es normal.
- En el LSI existe una imagen redondada, bien definida a nivel del 5º arco costal y en situación medial que puede confundirnos con un nódulo. Hay que estar atentos, en realidad se trata de la confluencia que forma la articulación esterno-clavicular entre la primera costilla y el esternón, suele ocurrir a nivel de T4 – T5. Es el denominado seudonódulo de la primera costilla.

CASO: Paciente con astenia y pérdida de peso. AP: fumador activo de 2 paquetes/día.


Hallazgos:
- Se observa una imágen nodular en LSD, a descartar proceso neoformativo.
- Pinzamiento del seno costofrénico derecho.
NÓDULO vs MASA PULMONAR:
- Un nódulo pulmonar solitario se describe como un aumento de densidad redondeada, bien definido e inferior o igual a 3 cm de diámetro, totalmente rodeado de parénquima, el cual no toca el hilio o el mediastino y que no está asociado a adenopatías atelectasias o engrosamiento pleural.
- Lesiones superiores 3 cm se consideran masas y deben ser consideradas malignas hasta no demostrar lo contrario.

CAUSAS DE PATRÓN NODULAR:
- INFLAMACIÓN / INFECCIÓN
- Granuloma
- TUMORES MALIGNOS
- Ca. broncogénico, metástasis
- TUMORES BENIGNOS
- Hamartoma, Lipoma, Fibroma
- VASCULAR
- MAV, Hemangioma, Infarto organizado
- CONGÉNITA
- Quiste broncogénico
- POR INHALACIÓN
- Silicosis, Aspergilosis alérgica
- PSEUDOMASAS
- Liquido en una cisura interlobar, Masa pleural, Artefactos
CASO: Fumadora de 3 paquetes/día con astenia y sensación disneica.


Hallazgos:
- Masa de 3.5 cm en LSD.
- Nódulo de localización medial en la base el hemitórax derecho.
- Atelectasia laminar en LII.
- Se recomienda realizar TC de tórax.
NOTA: Un nódulo pulmonar intraparenquimatoso es visible en las dos proyecciones de la placa simple, conservando su morfología y diámetros.

CASO: Paciente con cáncer de mama a revisión.



Hallazgos:
- Se observa una asimetría mamaria debida derecha debido a cambios postquirúrgicos.
- En el parénquima pulmonare visible parece no existir alteraciones a excepción de una imagen nodular periférica en base derecha. ¿Estamos ante un nódulo pulmonar? Analicemos la radiografía con detenemiento.


Ambas flechas señalan los pezones mamarios. Se observa que la imagen nodular es bilareral y en la placa lateral, es clara su posición en la glándula mamaria y no en el parénquima pulmonar. Cuando no lo tengamos claro, podemos recurrir a colocar un clip u otro objeto metálico sobre el pezón para así salir de dudas.
CASO: Paciente con antecedentes de cáncer de útero. Revisión.


Hallazgos:
- Se observan múltiples nódulos en ambos hemitórax. Es el signo de la suelta de globos en relación con metástasis.

SUELTA DE GLOBOS:
Son múltiples nódulos pulmonares bien definidos de distribución bilateral y aleatoria y con diferentes tamaños. Sugieren metástasis pulmonares.
CASO: Disnea.


Hallazgos:
- Multiples nódulos disperos y bilaterales conformando un claro patrón en suelta de globos.
CAUSAS DE PATRÓN NODULAR:
Recordemos que un nódulo se define como opacidades redondeadas, bien o mal delimitadas y que pueden ser únicos o múltiples, los cuales miden menos de 3 cm. Si son mayores de 3cm se consideran masas. Puede ser debido a:
- INFLAMACIÓN / INFECCIÓN
- Granuloma
- TUMORES MALIGNOS
- Ca. broncogénico, metástasis
- TUMORES BENIGNOS
- Hamartoma, Lipoma, Fibroma
- VASCULAR
- MAV, Hemangioma, Infarto organizado
- CONGÉNITA
- Quiste broncogénico
- POR INHALACIÓN
- Silicosis, Aspergilosis alérgica
- PSEUDOMASAS
- Liquido en una cisura interlobar, Masa pleural, Artefactos
CASO: Tos seca de más de 2 semanas y fiebre. Anorexia con discreta pérdida de peso. Mantoux positivo.


Hallazgos:
- Se observa un nódulo de cavitado de paredes bien definidas en el LSD que puede corresponder a infección tuberculosa dada la clínica existente.
CAUSAS DE NÓDULOS PULMONARES CAVITADOS.
- NEOPLASIAS
- Carcinoma de células escamosas
- Adenocarcinoma
- Metástasis
- ENFERMEDADES COLÁGENO-VASCULARES
- Granulomatosis de Wegener
- ENFERMEDADES GRANULOMATOSAS
- Histiocitosis X
- ENFERMEDAD VASCULAR
- Embolismo pulmonar con infarto
- INFECCIÓN
- TBC, Nocardiosis, criptococosis, coccidioidomicosis
- TRAUMATISMO
- Quiste pulmonar traumático
- ENFERMEDAD BRONCOPULMONAR
- Bulla infectada.
Veamos otro caso con tos, fiebre y mantoux postivo


CASO: Paciente oncológico con síntomas de neumonía.


Hallazgos:
- Aumento de densidad en base izquierda en relación con condensación neumónica.
- Catéter reservorio en hemitórax derecho con extremo en vena cava superior.
- Múltiples áreas radiolúcidas en el esqueleto visible en relación con lesiones lucentes mal definidas compatibles con metástasis óseas.
NOTA SOBRE LESIONES RADIOLUCENTES EN LOS HUESOS:
- Cuando la lesión crece despacio, el hueso tendrá tiempo suficiente para aislarse de la lesión, eliminando algún hueso alrededor de la lesión y además formando nuevo hueso alrededor de los márgenes de la lesión. Esto produce una esclerosis y un margen bien definido. Si la lesión crece más rápido, el hueso sólo puede tener tiempo para retirarse de la misma, y no tiene tiempo a formar un márgen de esclerosis.
- Las lesiones solitarias radiolucentes del hueso con un margen distinguible se llaman lesiones geográficas, tanto si tienen o no un margen de esclerosis.
- Si la lesión crece todavía más rápido, el hueso no tiene tiempo para retirarse de una manera ordenada, y el margen queda mal definido. En lugar de una sola lesión discreta, podemos ver algunos focos de lucencia mal definidos formando el clásico patrón «apolillado».
- Si el proceso crece más rápidamente todavía, entonces la retirada del hueso puede hacerse de forma desordenada. El límite entre el hueso normal y el anormal puede perderse totalmente, con sólo un patrón muy mal definido de radiolucencia, causado por muchos agujeros pequeños, irregulares en el hueso, dejados atrás por los osteoclastos. Éste es un modelo sumamente agresivo, a veces llamado patrón «permeativo».




Deja un comentario